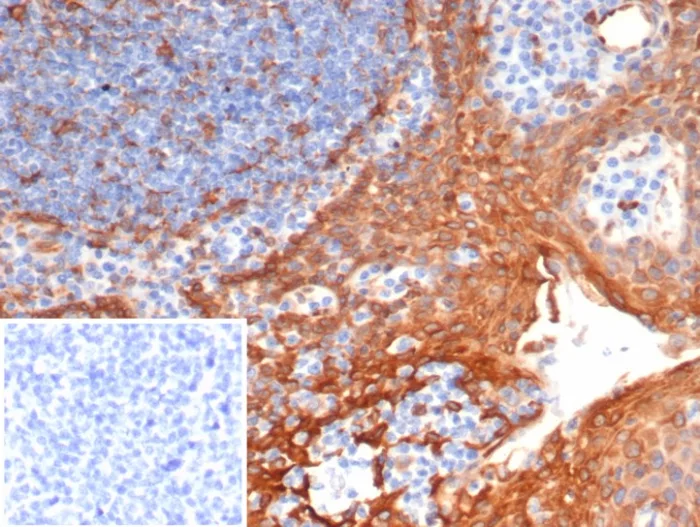

Formalin-fixed, paraffin-embedded human tonsil stained with STING1 Mouse Monoclonal Antibody (STING1/7435). Inset: PBS instead of primary antibody; secondary only negative control.

Western Blot Analysis of HDLM-2 lysate using STING1 Mouse Monoclonal Antibody (STING1/7435).
TMEM17 (transmembrane protein 173) is a 379 amino acid protein encoded by a gene mapping to human chromosome 5. With 181 million base pairs encoding around 1,000 genes, chromosome 5 is about 6% of human genomic DNA. It is associated with Cockayne syndrome through the ERCC8 gene and familial adenomatous polyposis through the adenomatous polyposis coli (APC) tumor suppressor gene. Treacher Collins syndrome is also chromosome 5 associated and is caused by insertions or deletions within the TCOF1 gene. Deletion of the p arm of chromosome 5 leads to Cri du chat syndrome. Deletion of 5q or chromosome 5 altogether is common in therapy-related acute myelogenous leukemias and myelodysplastic syndrome.
There are no reviews yet.